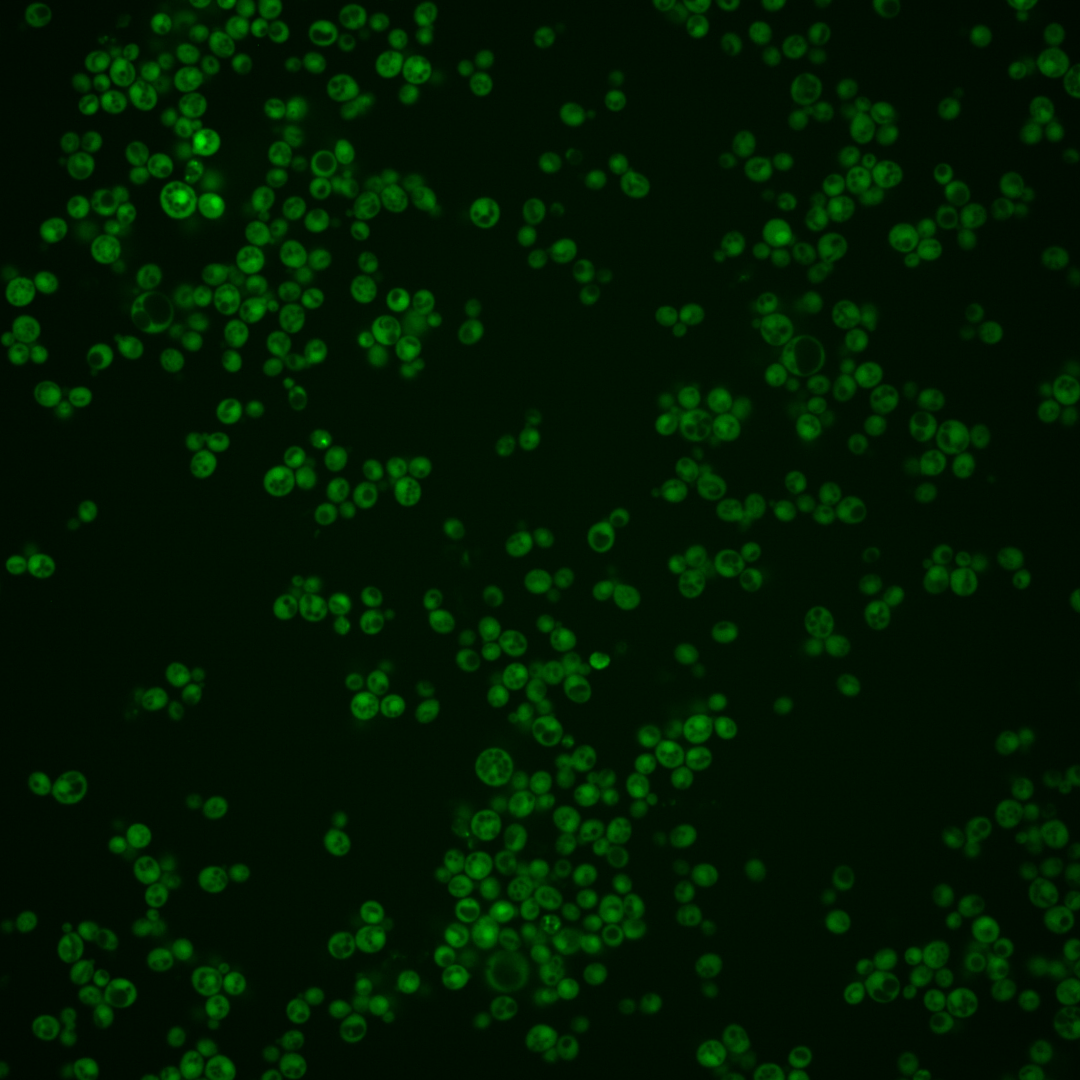
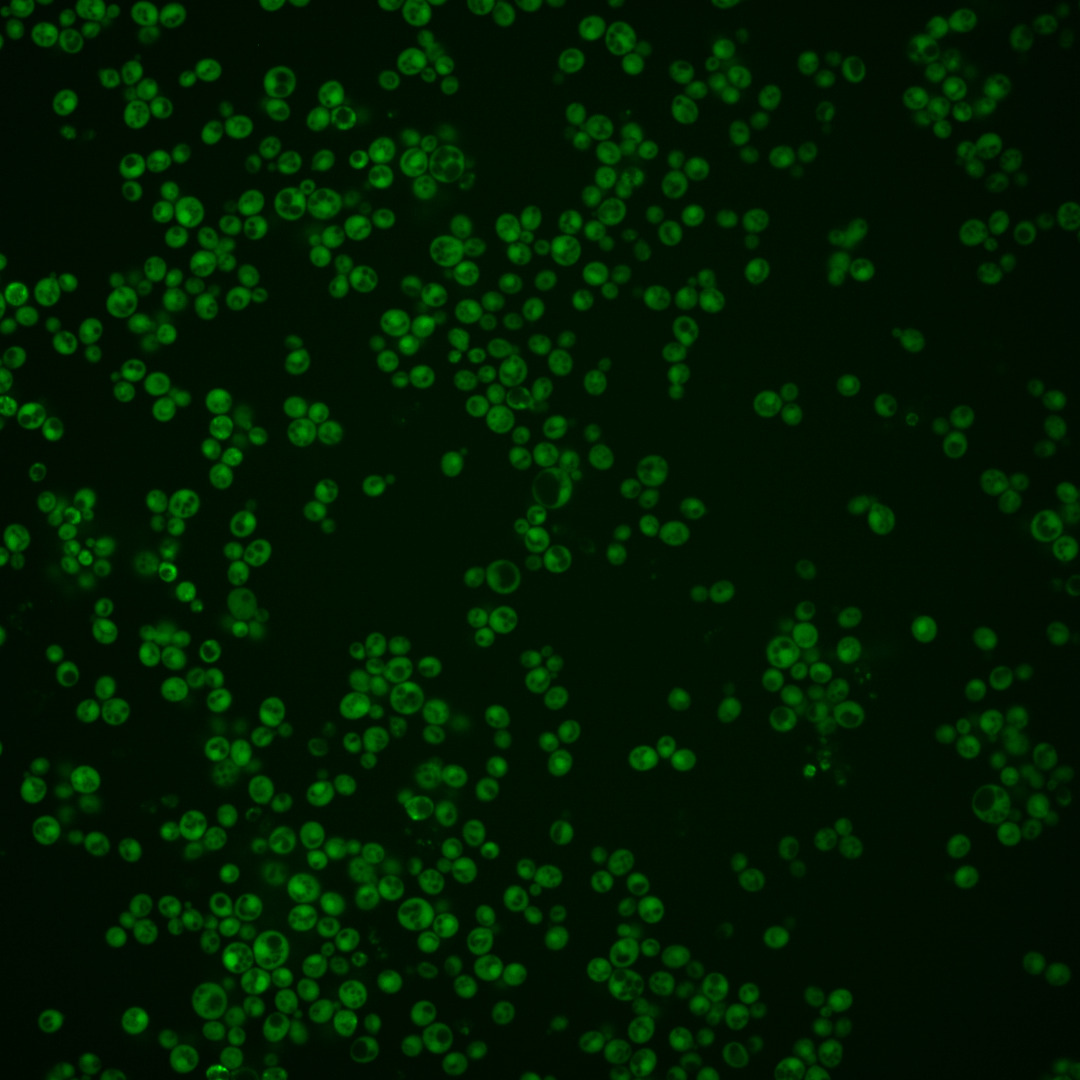
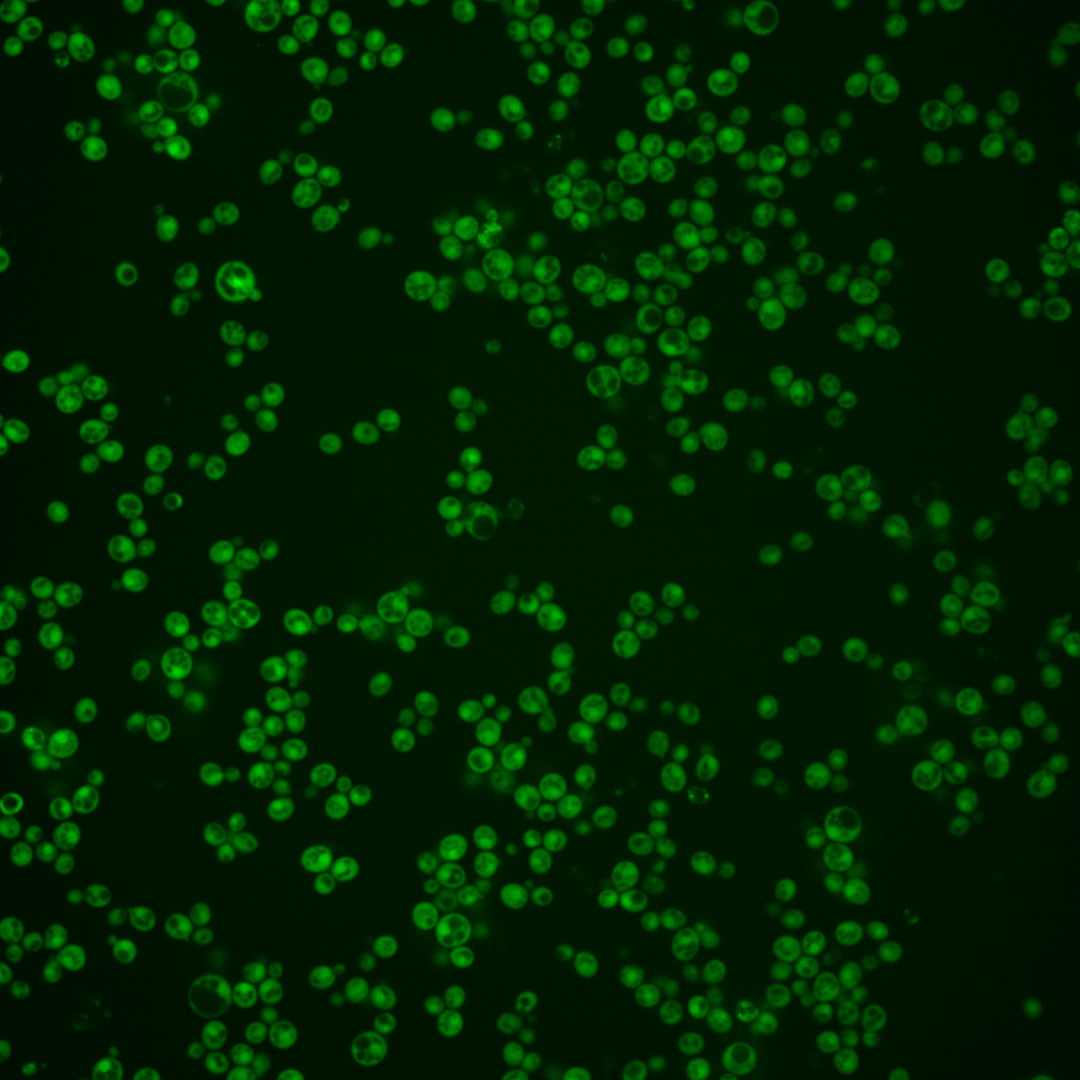
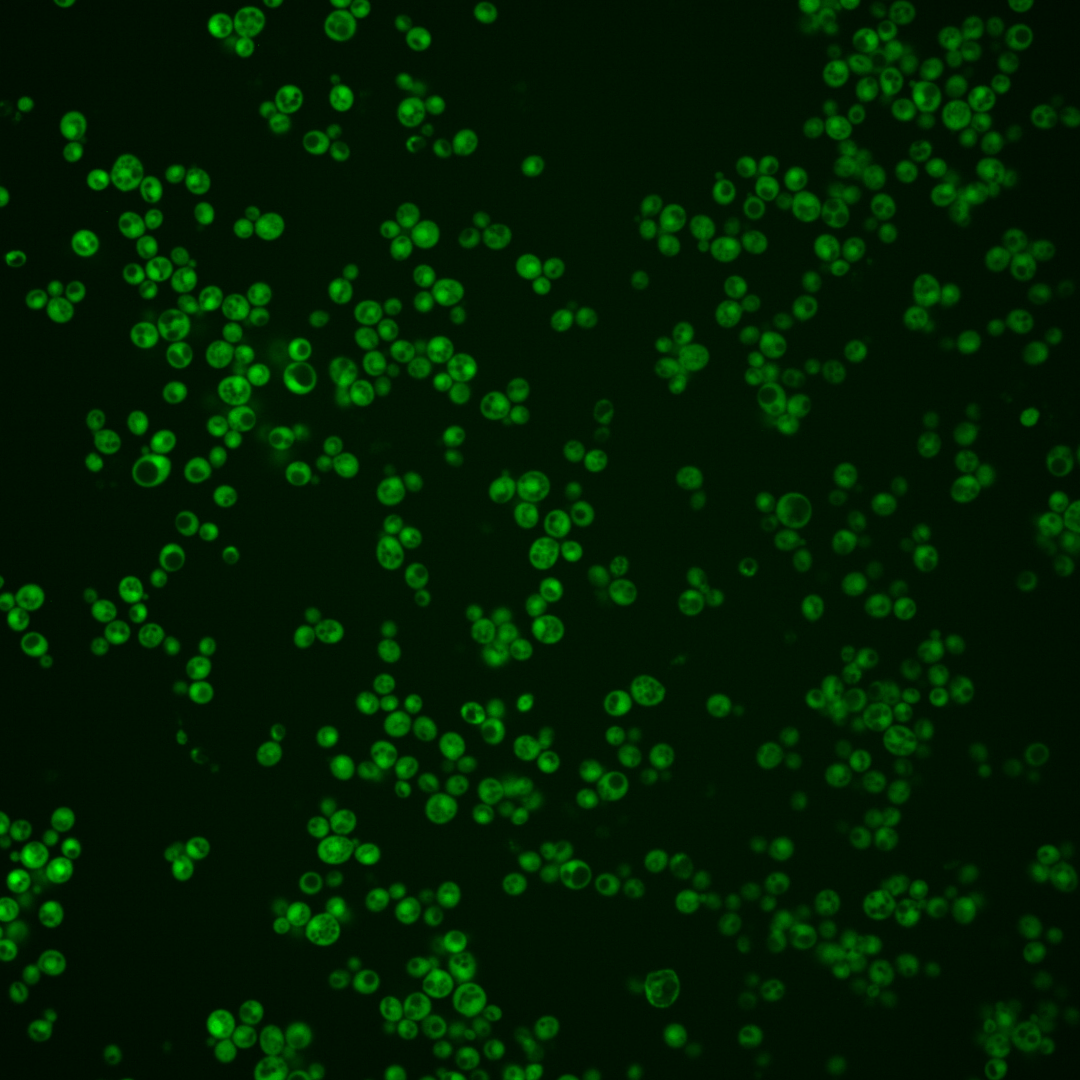
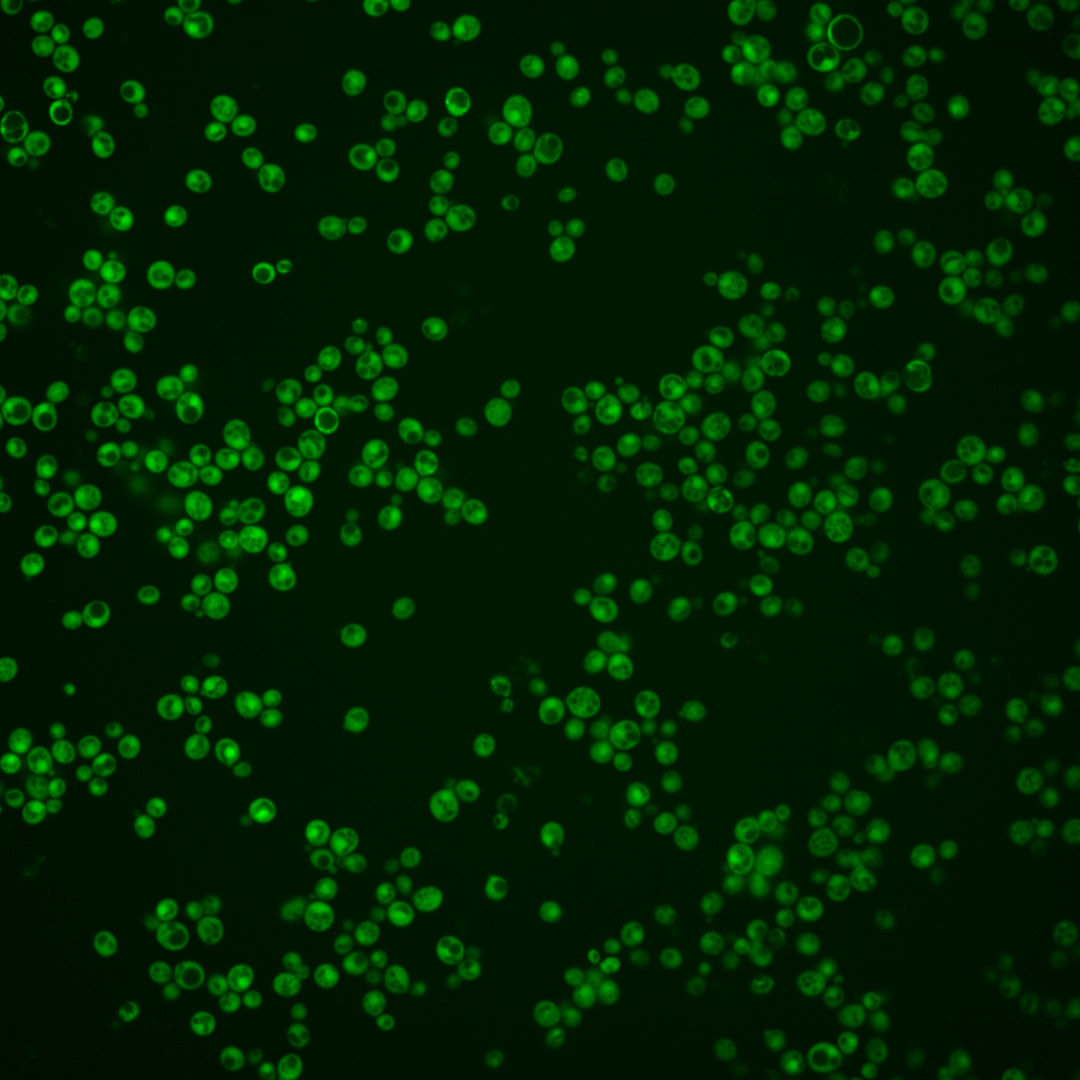
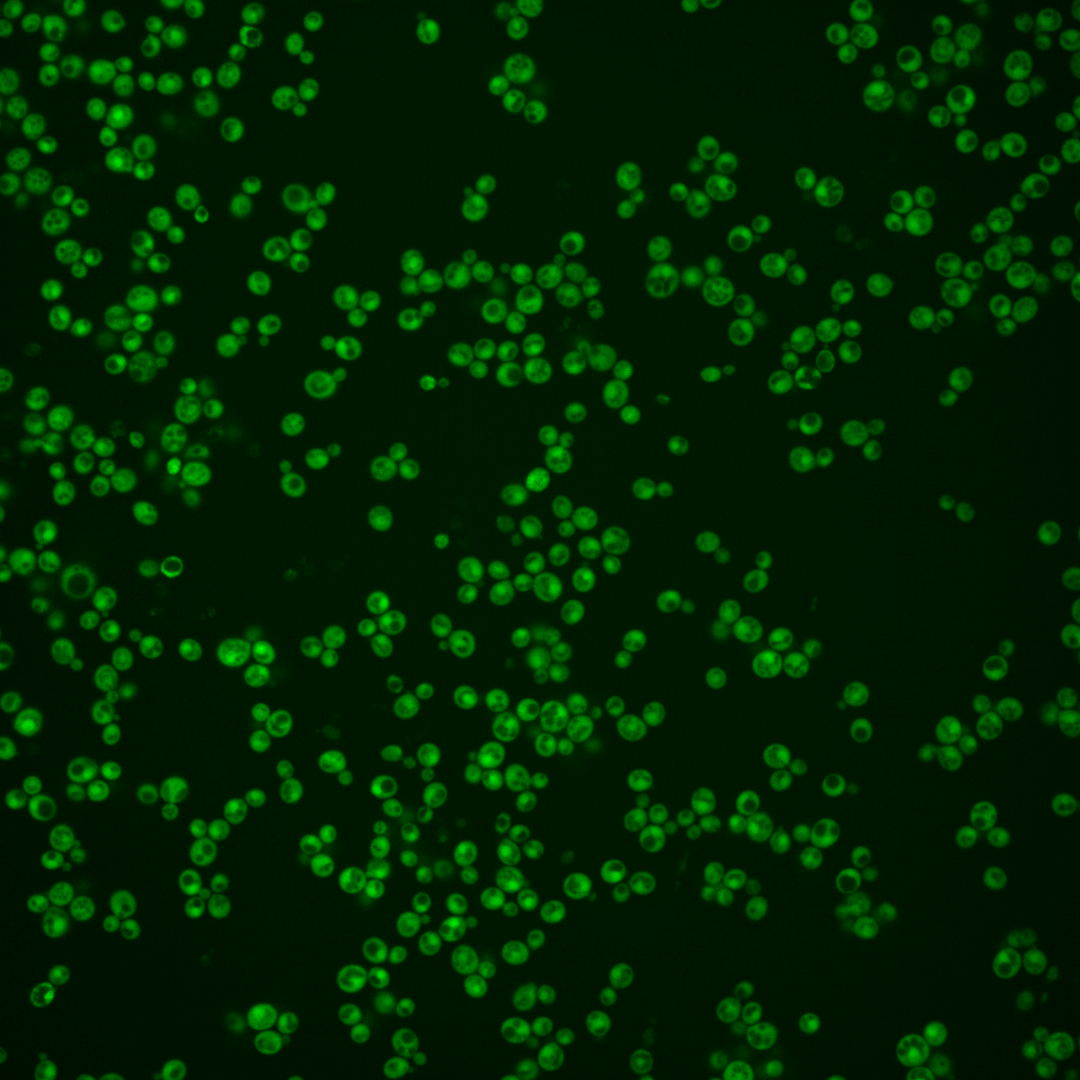
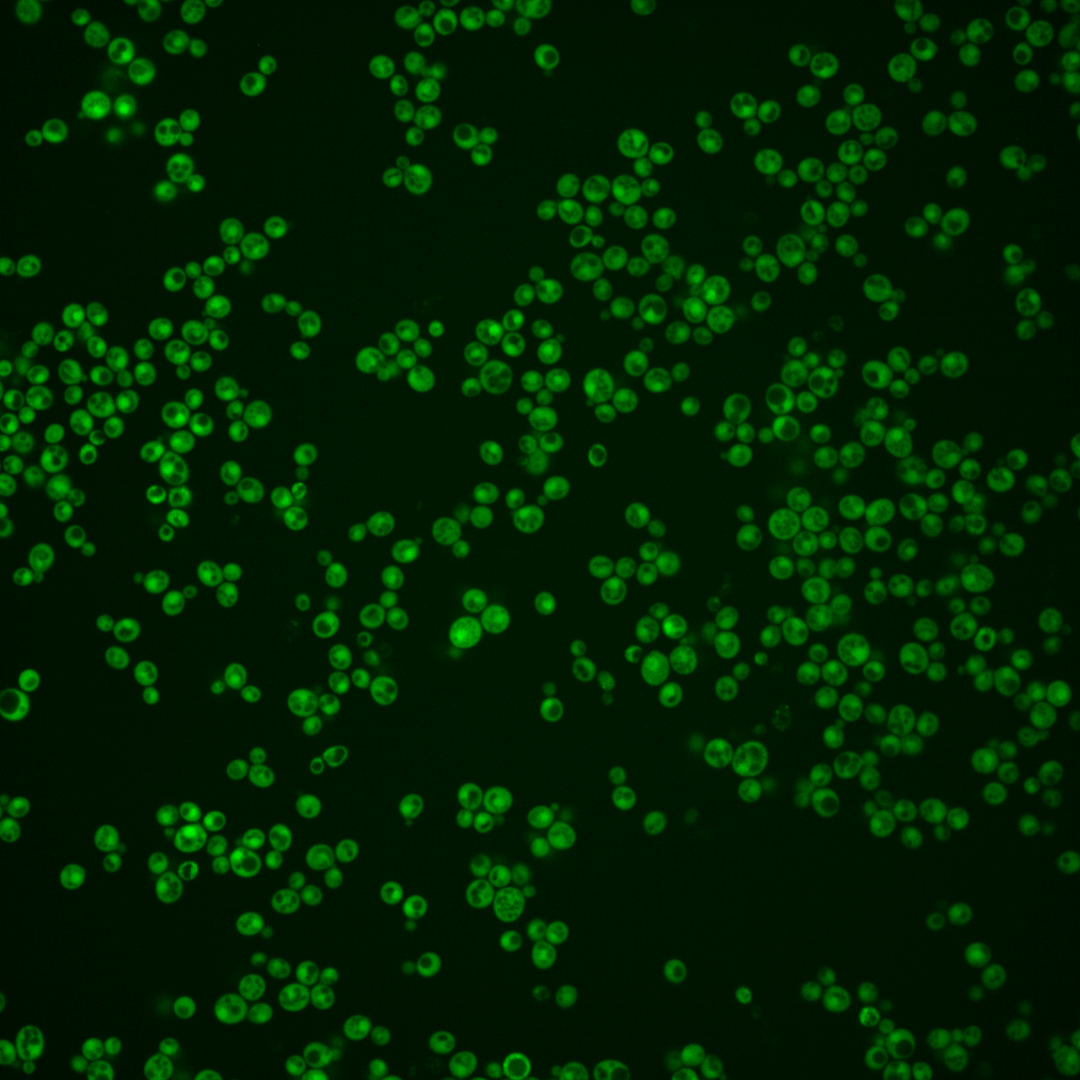

| Standard name | |
|---|---|
| Human Ortholog | |
| Description | Golgi phosphatidylinositol-4-kinase effector and PtdIns4P sensor; interacts with the cytosolic domains of cis and medial glycosyltransferases, and in the PtdIns4P-bound state mediates the targeting of these enzymes to the Golgi; interacts with the catalytic domain of Sac1p, the major cellular PtdIns4P phosphatase, to direct dephosphosphorylation of the Golgi pool of PtdIns4P; tetramerization required for function; ortholog of human GOLPH3/GPP34/GMx33 |
Micrographs




















































































Sub-cellular Localization
Yeast GFP Assignment
Protein Abundance
Localization Change
External localization resources
| ensLOC | DeepLoc | |||||||||||||||||||||||
|---|---|---|---|---|---|---|---|---|---|---|---|---|---|---|---|---|---|---|---|---|---|---|---|---|
| Localization | WT1 | WT2 | WT3 | RAP60 | RAP140 | RAP220 | RAP300 | RAP380 | RAP460 | RAP540 | RAP620 | RAP700 | HU80 | HU120 | HU160 | rpd3Δ_1 | rpd3Δ_2 | rpd3Δ_3 | WT1 | WT2 | WT3 | AF100 | AF140 | AF180 |
| Cortical Patches | 0 | – | – | 0 | 0 | – | 0 | 1 | 0 | 0 | – | 0 | 0 | 0 | 0 | 0 | 0 | 0 | 0 | 0 | 0 | 0 | 0 | 0 |
| Bud | 0 | – | – | 0 | 0 | – | 0 | 0 | 0 | 0 | – | 1 | 1 | 0 | 0 | 0 | 0 | 0 | 0 | 2 | 0 | 0 | 0 | 3 |
| Bud Neck | 0 | – | – | 0 | 0 | – | 0 | 0 | 0 | 0 | – | 0 | 0 | 0 | 0 | 0 | 0 | 0 | 0 | 0 | 0 | 0 | 0 | 1 |
| Bud Site | 0 | – | – | 0 | 0 | – | 0 | 0 | 0 | 0 | – | 0 | 0 | 0 | 0 | 0 | 0 | 0 | – | – | – | – | – | – |
| Cell Periphery | 0 | – | – | 0 | 0 | – | 0 | 0 | 1 | 0 | – | 0 | 0 | 0 | 1 | 0 | 0 | 3 | 0 | 0 | 1 | 0 | 0 | 0 |
| Cytoplasm | 117 | – | – | 11 | 40 | – | 92 | 64 | 34 | 32 | – | 31 | 116 | 119 | 118 | 34 | 15 | 36 | 110 | 42 | 22 | 63 | 105 | 147 |
| Endoplasmic Reticulum | 0 | – | – | 0 | 0 | – | 0 | 4 | 0 | 0 | – | 1 | 0 | 0 | 1 | 1 | 0 | 1 | 0 | 0 | 0 | 0 | 1 | 1 |
| Endosome | 0 | – | – | 0 | 0 | – | 0 | 0 | 0 | 0 | – | 0 | 0 | 0 | 0 | 0 | 0 | 0 | 0 | 0 | 0 | 0 | 0 | 1 |
| Golgi | 0 | – | – | 0 | 0 | – | 0 | 0 | 0 | 0 | – | 0 | 0 | 0 | 0 | 1 | 1 | 2 | 0 | 0 | 0 | 0 | 0 | 1 |
| Mitochondria | 1 | – | – | 0 | 1 | – | 1 | 2 | 1 | 3 | – | 0 | 0 | 1 | 0 | 1 | 0 | 1 | 1 | 1 | 0 | 0 | 1 | 1 |
| Nucleus | 0 | – | – | 0 | 0 | – | 0 | 0 | 1 | 1 | – | 2 | 0 | 1 | 0 | 0 | 0 | 1 | 8 | 14 | 2 | 9 | 8 | 10 |
| Nuclear Periphery | 0 | – | – | 0 | 0 | – | 0 | 0 | 0 | 0 | – | 0 | 0 | 0 | 0 | 0 | 0 | 0 | 0 | 0 | 0 | 0 | 0 | 0 |
| Nucleolus | 0 | – | – | 0 | 0 | – | 2 | 0 | 0 | 0 | – | 0 | 0 | 0 | 0 | 0 | 0 | 0 | 0 | 0 | 0 | 0 | 0 | 0 |
| Peroxisomes | 0 | – | – | 0 | 0 | – | 0 | 0 | 0 | 0 | – | 0 | 0 | 0 | 0 | 0 | 0 | 0 | 0 | 0 | 0 | 0 | 0 | 0 |
| SpindlePole | 0 | – | – | 0 | 0 | – | 0 | 0 | 0 | 0 | – | 0 | 0 | 0 | 0 | 0 | 0 | 0 | 0 | 0 | 0 | 0 | 0 | 0 |
| Vac/Vac Membrane | 4 | – | – | 8 | 38 | – | 10 | 11 | 9 | 26 | – | 7 | 1 | 1 | 7 | 21 | 1 | 24 | 2 | 2 | 0 | 3 | 0 | 5 |
| Unique Cell Count | 119 | 17 | 71 | 103 | 80 | 42 | 60 | 39 | 116 | 121 | 124 | 49 | 17 | 60 | 126 | 65 | 30 | 81 | 124 | 179 | ||||
| Labelled Cell Count | 122 | 19 | 79 | 105 | 82 | 46 | 62 | 42 | 118 | 122 | 127 | 58 | 17 | 68 | 126 | 65 | 30 | 81 | 124 | 179 | ||||
Yeast GFP Assignment
Protein Abundance
| Screen | WT1 | WT2 | WT3 | RAP60 | RAP140 | RAP220 | RAP300 | RAP380 | RAP460 | RAP540 | RAP620 | RAP700 | HU80 | HU120 | HU160 | rpd3Δ_1 | rpd3Δ_2 | rpd3Δ_3 | AF100 | AF140 | AF180 |
|---|---|---|---|---|---|---|---|---|---|---|---|---|---|---|---|---|---|---|---|---|---|
| Mean Cell GFP Intensity (1e-4) | 10.3 | – | – | 11.8 | 12.1 | – | 11.6 | 12.1 | 12.2 | 9.7 | – | 10.9 | 13.5 | 13.5 | 12.9 | 14.8 | 15.9 | 15.5 | 10.5 | 11.7 | 13.1 |
| Std Deviation (1e-4) | 1.8 | – | – | 1.4 | 1.9 | – | 2.7 | 2.8 | 2.7 | 2.3 | – | 2.5 | 2.0 | 1.8 | 2.0 | 3.2 | 2.6 | 4.7 | 2.0 | 2.3 | 3.0 |
| Intensity Change (Log2) | – | – | – | – | – | – | – | – | – | – | – | – | – | – | – | – | – | – | – | – | – |
Localization Change
| Localization | RAP60 | RAP140 | RAP220 | RAP300 | RAP380 | RAP460 | RAP540 | RAP620 | RAP700 | HU80 | HU120 | HU160 | rpd3Δ_1 | rpd3Δ_2 | rpd3Δ_3 |
|---|---|---|---|---|---|---|---|---|---|---|---|---|---|---|---|
| Actin | – | – | – | – | – | – | – | – | – | – | – | – | – | – | – |
| Bud | – | – | – | – | – | – | – | – | – | – | – | – | – | – | – |
| Bud Neck | – | – | – | – | – | – | – | – | – | – | – | – | – | – | – |
| Bud Site | – | – | – | – | – | – | – | – | – | – | – | – | – | – | – |
| Cell Periphery | – | – | – | – | – | – | – | – | – | – | – | – | – | – | – |
| Cyto | – | – | – | – | – | – | – | – | – | – | – | – | – | – | – |
| Endoplasmic Reticulum | – | – | – | – | – | – | – | – | – | – | – | – | – | – | – |
| Endosome | – | – | – | – | – | – | – | – | – | – | – | – | – | – | – |
| Golgi | – | – | – | – | – | – | – | – | – | – | – | – | – | – | – |
| Mitochondria | – | – | – | – | – | – | – | – | – | – | – | – | – | – | – |
| Nuclear Periphery | – | – | – | – | – | – | – | – | – | – | – | – | – | – | – |
| Nuc | – | – | – | – | – | – | – | – | – | – | – | – | – | – | – |
| Nucleolus | – | – | – | – | – | – | – | – | – | – | – | – | – | – | – |
| Peroxisomes | – | – | – | – | – | – | – | – | – | – | – | – | – | – | – |
| SpindlePole | – | – | – | – | – | – | – | – | – | – | – | – | – | – | – |
| Vac | – | – | – | – | – | – | – | – | – | – | – | – | – | – | – |
| Cortical Patches | – | – | – | – | – | – | – | – | – | – | – | – | – | – | – |
| Cytoplasm | – | – | – | – | – | – | – | – | – | – | – | – | – | – | – |
| Nucleus | – | – | – | – | – | – | – | – | – | – | – | – | – | – | – |
| Vacuole | – | – | – | – | – | – | – | – | – | – | – | – | – | – | – |
External localization resources
Images






























Protein Concentration and Protein Localization Data
| R1 | R2 | R3 | ||||||||||||||||
|---|---|---|---|---|---|---|---|---|---|---|---|---|---|---|---|---|---|---|
| G1 Pre-START | G1 Post-START | S/G2 | Metaphase | Anaphase | Telophase | G1 Pre-START | G1 Post-START | S/G2 | Metaphase | Anaphase | Telophase | G1 Pre-START | G1 Post-START | S/G2 | Metaphase | Anaphase | Telophase | |
| Concentration | 10.6714 | 14.9788 | 12.8277 | 10.8387 | 10.7638 | 12.7733 | 11.1981 | 15.0242 | 13.4358 | 12.8596 | 12.3887 | 12.9551 | 8.2638 | 12.7851 | 11.2947 | 9.6772 | 9.6919 | 11.7823 |
| Actin | 0.0145 | 0.0011 | 0.0122 | 0.0036 | 0.0205 | 0.002 | 0.0024 | 0.0001 | 0.0001 | 0.0001 | 0.0009 | 0.0001 | 0.0495 | 0.0004 | 0.0126 | 0.0945 | 0.0035 | 0.0003 |
| Bud | 0.0003 | 0.0003 | 0.0005 | 0.0006 | 0.0003 | 0.0002 | 0.0001 | 0.0001 | 0.0001 | 0.0001 | 0.0001 | 0.0001 | 0.0009 | 0.0004 | 0.0003 | 0.0003 | 0.0003 | 0.0001 |
| Bud Neck | 0.0007 | 0.0005 | 0.0008 | 0.0014 | 0.001 | 0.0022 | 0.0006 | 0.0004 | 0.0003 | 0.0006 | 0.0009 | 0.0018 | 0.0013 | 0.0003 | 0.0006 | 0.0005 | 0.0006 | 0.0013 |
| Bud Periphery | 0.0004 | 0.0001 | 0.0007 | 0.0005 | 0.0002 | 0.0001 | 0.0001 | 0 | 0 | 0 | 0.0001 | 0 | 0.0009 | 0.0001 | 0.0002 | 0.0002 | 0.0002 | 0 |
| Bud Site | 0.0014 | 0.0018 | 0.0012 | 0.0014 | 0.0004 | 0.0003 | 0.0002 | 0.0002 | 0.0001 | 0 | 0.0001 | 0.0001 | 0.0054 | 0.0009 | 0.001 | 0.0012 | 0.0005 | 0 |
| Cell Periphery | 0.0001 | 0.0001 | 0.0002 | 0.0002 | 0.0001 | 0.0001 | 0 | 0 | 0 | 0 | 0 | 0 | 0.0004 | 0.0001 | 0.0001 | 0 | 0 | 0 |
| Cytoplasm | 0.2444 | 0.4065 | 0.2457 | 0.2826 | 0.1567 | 0.2741 | 0.2557 | 0.3649 | 0.2624 | 0.3351 | 0.3185 | 0.2425 | 0.2231 | 0.5558 | 0.4925 | 0.3409 | 0.3173 | 0.366 |
| Cytoplasmic Foci | 0.0083 | 0.0044 | 0.0075 | 0.0125 | 0.0089 | 0.0051 | 0.0034 | 0.0007 | 0.0002 | 0.0006 | 0.0019 | 0.0044 | 0.0325 | 0.0091 | 0.0049 | 0.0007 | 0.0274 | 0.0002 |
| Eisosomes | 0.0001 | 0 | 0.0001 | 0 | 0.0001 | 0 | 0 | 0 | 0 | 0 | 0 | 0 | 0.0004 | 0 | 0.0001 | 0.0001 | 0 | 0 |
| Endoplasmic Reticulum | 0.0063 | 0.0009 | 0.0045 | 0.0127 | 0.0051 | 0.0029 | 0.0029 | 0.0007 | 0.0007 | 0.0004 | 0.0015 | 0.0016 | 0.007 | 0.0015 | 0.0062 | 0.0006 | 0.002 | 0.0008 |
| Endosome | 0.0343 | 0.0024 | 0.0158 | 0.0695 | 0.0622 | 0.0146 | 0.0043 | 0.0004 | 0.0003 | 0.0002 | 0.0199 | 0.0022 | 0.0385 | 0.0172 | 0.0124 | 0.0003 | 0.0924 | 0.0002 |
| Golgi | 0.0072 | 0.0015 | 0.0062 | 0.0047 | 0.0418 | 0.0126 | 0.0004 | 0 | 0 | 0 | 0.0035 | 0.0008 | 0.0216 | 0.0016 | 0.0103 | 0.0012 | 0.0809 | 0 |
| Lipid Particles | 0.0055 | 0.0007 | 0.0039 | 0.0057 | 0.0037 | 0.0057 | 0.0014 | 0 | 0 | 0 | 0.0067 | 0.0003 | 0.0233 | 0.0018 | 0.0022 | 0.0002 | 0.0048 | 0 |
| Mitochondria | 0.0058 | 0.001 | 0.0043 | 0.0062 | 0.0446 | 0.0177 | 0.0005 | 0.0002 | 0.0002 | 0.0001 | 0.0066 | 0.0002 | 0.0173 | 0.0006 | 0.0038 | 0.0014 | 0.004 | 0.0002 |
| None | 0.0013 | 0.0002 | 0.0004 | 0.0015 | 0.0005 | 0.0003 | 0.0013 | 0.0006 | 0.0002 | 0.0004 | 0.0005 | 0.0003 | 0.0071 | 0.0007 | 0.0047 | 0.0003 | 0.0004 | 0.0002 |
| Nuclear Periphery | 0.0337 | 0.0177 | 0.0192 | 0.0175 | 0.0208 | 0.0183 | 0.027 | 0.0117 | 0.0153 | 0.0101 | 0.0134 | 0.0204 | 0.0362 | 0.0139 | 0.0182 | 0.0153 | 0.0264 | 0.0226 |
| Nucleolus | 0.0005 | 0.0001 | 0.0003 | 0.0006 | 0.0002 | 0.0003 | 0.0004 | 0.0002 | 0.0003 | 0.0001 | 0.0002 | 0.0003 | 0.0018 | 0.0002 | 0.0001 | 0.0002 | 0.0002 | 0.0002 |
| Nucleus | 0.6233 | 0.5582 | 0.6607 | 0.5647 | 0.6256 | 0.6362 | 0.6881 | 0.6169 | 0.7172 | 0.6501 | 0.6202 | 0.72 | 0.5001 | 0.3909 | 0.4174 | 0.5392 | 0.43 | 0.6056 |
| Peroxisomes | 0.0025 | 0.0006 | 0.0103 | 0.0029 | 0.0014 | 0.0021 | 0.0023 | 0 | 0 | 0 | 0.0008 | 0.0004 | 0.0165 | 0.0002 | 0.0093 | 0.0009 | 0.002 | 0 |
| Punctate Nuclear | 0.0031 | 0.0011 | 0.0025 | 0.0031 | 0.002 | 0.0027 | 0.0073 | 0.0025 | 0.002 | 0.0018 | 0.0022 | 0.003 | 0.0114 | 0.0018 | 0.0018 | 0.0015 | 0.0032 | 0.0017 |
| Vacuole | 0.0047 | 0.0007 | 0.0025 | 0.006 | 0.0024 | 0.0018 | 0.0013 | 0.0005 | 0.0004 | 0.0002 | 0.0013 | 0.0013 | 0.0032 | 0.0022 | 0.0007 | 0.0003 | 0.0024 | 0.0004 |
| Vacuole Periphery | 0.0014 | 0.0002 | 0.0007 | 0.0023 | 0.0014 | 0.0005 | 0.0003 | 0.0001 | 0.0001 | 0.0001 | 0.0009 | 0.0002 | 0.0016 | 0.0003 | 0.0006 | 0.0002 | 0.0013 | 0.0002 |
Sequencing Data
| R1 | R2 | |||||||||
|---|---|---|---|---|---|---|---|---|---|---|
| G1 Post-START | S/G2 | Metaphase | Anaphase | Telophase | G1 Post-START | S/G2 | Metaphase | Anaphase | Telophase | |
| Gene Expression | 89.8244 | 66.5186 | 71.219 | 67.329 | 60.6425 | 90.3058 | 67.4971 | 73.9272 | 58.3918 | 69.4003 |
| Translational Efficiency | 1.1911 | 1.4118 | 1.1682 | 1.3732 | 1.3072 | 1.3205 | 1.3076 | 1.1433 | 1.4412 | 1.1875 |
Hit Data
| Dataset | Hit |
|---|---|
| Protein Concentration | ✘ |
| Protein Localization | ✘ |
| Gene Expression | ✘ |
| Translational Efficiency | ✘ |
Endocytosis
| Temp | Actin Patch (Sac6-tdTomato) | Cortical Patch (Sla1-GFP) | Late Endosome (Snf7-GFP) | Vacuole (Vph1-GFP) |
|---|---|---|---|---|
| 37℃ | ||||
| RT |
Cell Cycle Omics
CYCLoPs (Vps74-GFP)
| Gene / Allele | Actin Patch (Sac6-tdTomato) | Cortical Patch (Sla1-GFP) | Late Endosome (Snf7-GFP) | Vacuole (Sac6-tdTomato) |
|---|
| Gene | Images |
|---|
| Gene | Images |
|---|
Images are not yet available
Images are not yet available